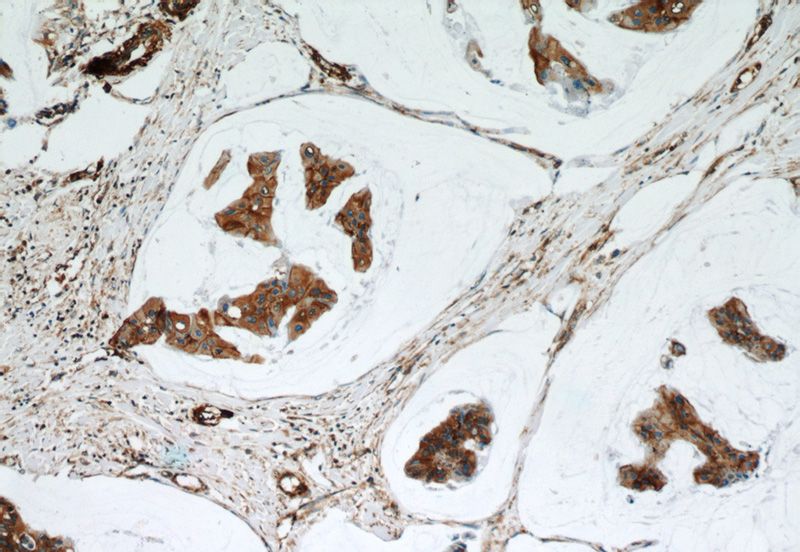
Immunohistochemical of paraffin-embedded human breast cancer using Catalog No:113309(NOTCH3 antibody) at dilution of 1:50 (under 10x lens)

-
Product Name
NOTCH3 antibody
- Documents
-
Description
NOTCH3 Rabbit Polyclonal antibody. Positive IHC detected in human breast cancer tissue, human lung tissue. Positive IP detected in HeLa cells. Positive WB detected in COLO 320 cells, HeLa cells. Observed molecular weight by Western-blot: 250-260 kDa, 100 kDa
-
Tested applications
ELISA, WB, IHC, IP
-
Species reactivity
Human,Mouse,Rat; other species not tested.
-
Alternative names
CADASIL antibody; CASIL antibody; Notch 3 antibody; Notch homolog 3 (Drosophila) antibody; NOTCH3 antibody
-
Isotype
Rabbit IgG
-
Preparation
This antibody was obtained by immunization of Peptide (Accession Number: NM_000435). Purification method: Antigen affinity purified.
-
Clonality
Polyclonal
-
Formulation
PBS with 0.02% sodium azide and 50% glycerol pH 7.3.
-
Storage instructions
Store at -20℃. DO NOT ALIQUOT
-
Applications
Recommended Dilution:
WB: 1:500-1:5000
IP: 1:200-1:2000
IHC: 1:20-1:200
-
Validations

COLO 320 cells were subjected to SDS PAGE followed by western blot with Catalog No:113309(NOTCH3 antibody) at dilution of 1:500
Immunohistochemical of paraffin-embedded human breast cancer using Catalog No:113309(NOTCH3 antibody) at dilution of 1:50 (under 10x lens)

Immunohistochemical of paraffin-embedded human breast cancer using Catalog No:113309(NOTCH3 antibody) at dilution of 1:50 (under 40x lens)

IP Result of anti-NOTCH3 (IP:Catalog No:113309, 4ug; Detection:Catalog No:113309 1:500) with HeLa cells lysate 2400ug.
-
Background
NOTCH3 belongs to the NOTCH family. It functions as a receptor for membrane-bound ligands Jagged1, Jagged2 and Delta1 to regulate cell-fate determination. Upon ligand activation through the released notch intracellular domain (NICD) it forms a transcriptional activator complex with RBP-J kappa and activates genes of the enhancer of split locus. NOTCH3 affects the implementation of differentiation, proliferation and apoptotic programs. Defects in NOTCH3 are the cause of cerebral autosomal dominant arteriopathy with subcortical infarcts and leukoencephalopathy (CADASIL). The antibody is specific to NOTCH3.
-
References
- Roher AE, Maarouf CL, Kokjohn TA. Neuropathological and biochemical assessments of an Alzheimer's disease patient treated with the γ-secretase inhibitor semagacestat. American journal of neurodegenerative disease. 3(3):115-33. 2014.
- Zhang S, Chung WC, Miele L, Xu K. Targeting Met and Notch in the Lfng-deficient, Met-amplified triple-negative breast cancer. Cancer biology & therapy. 15(5):633-42. 2014.
- Zhang S, Chung WC, Wu G, Egan SE, Miele L, Xu K. Manic fringe promotes a claudin-low breast cancer phenotype through notch-mediated PIK3CG induction. Cancer research. 75(10):1936-43. 2015.
- Zhang S, Chung WC, Xu K. Lunatic Fringe is a potent tumor suppressor in Kras-initiated pancreatic cancer. Oncogene. 2015.
Related Products / Services
Please note: All products are "FOR RESEARCH USE ONLY AND ARE NOT INTENDED FOR DIAGNOSTIC OR THERAPEUTIC USE"
